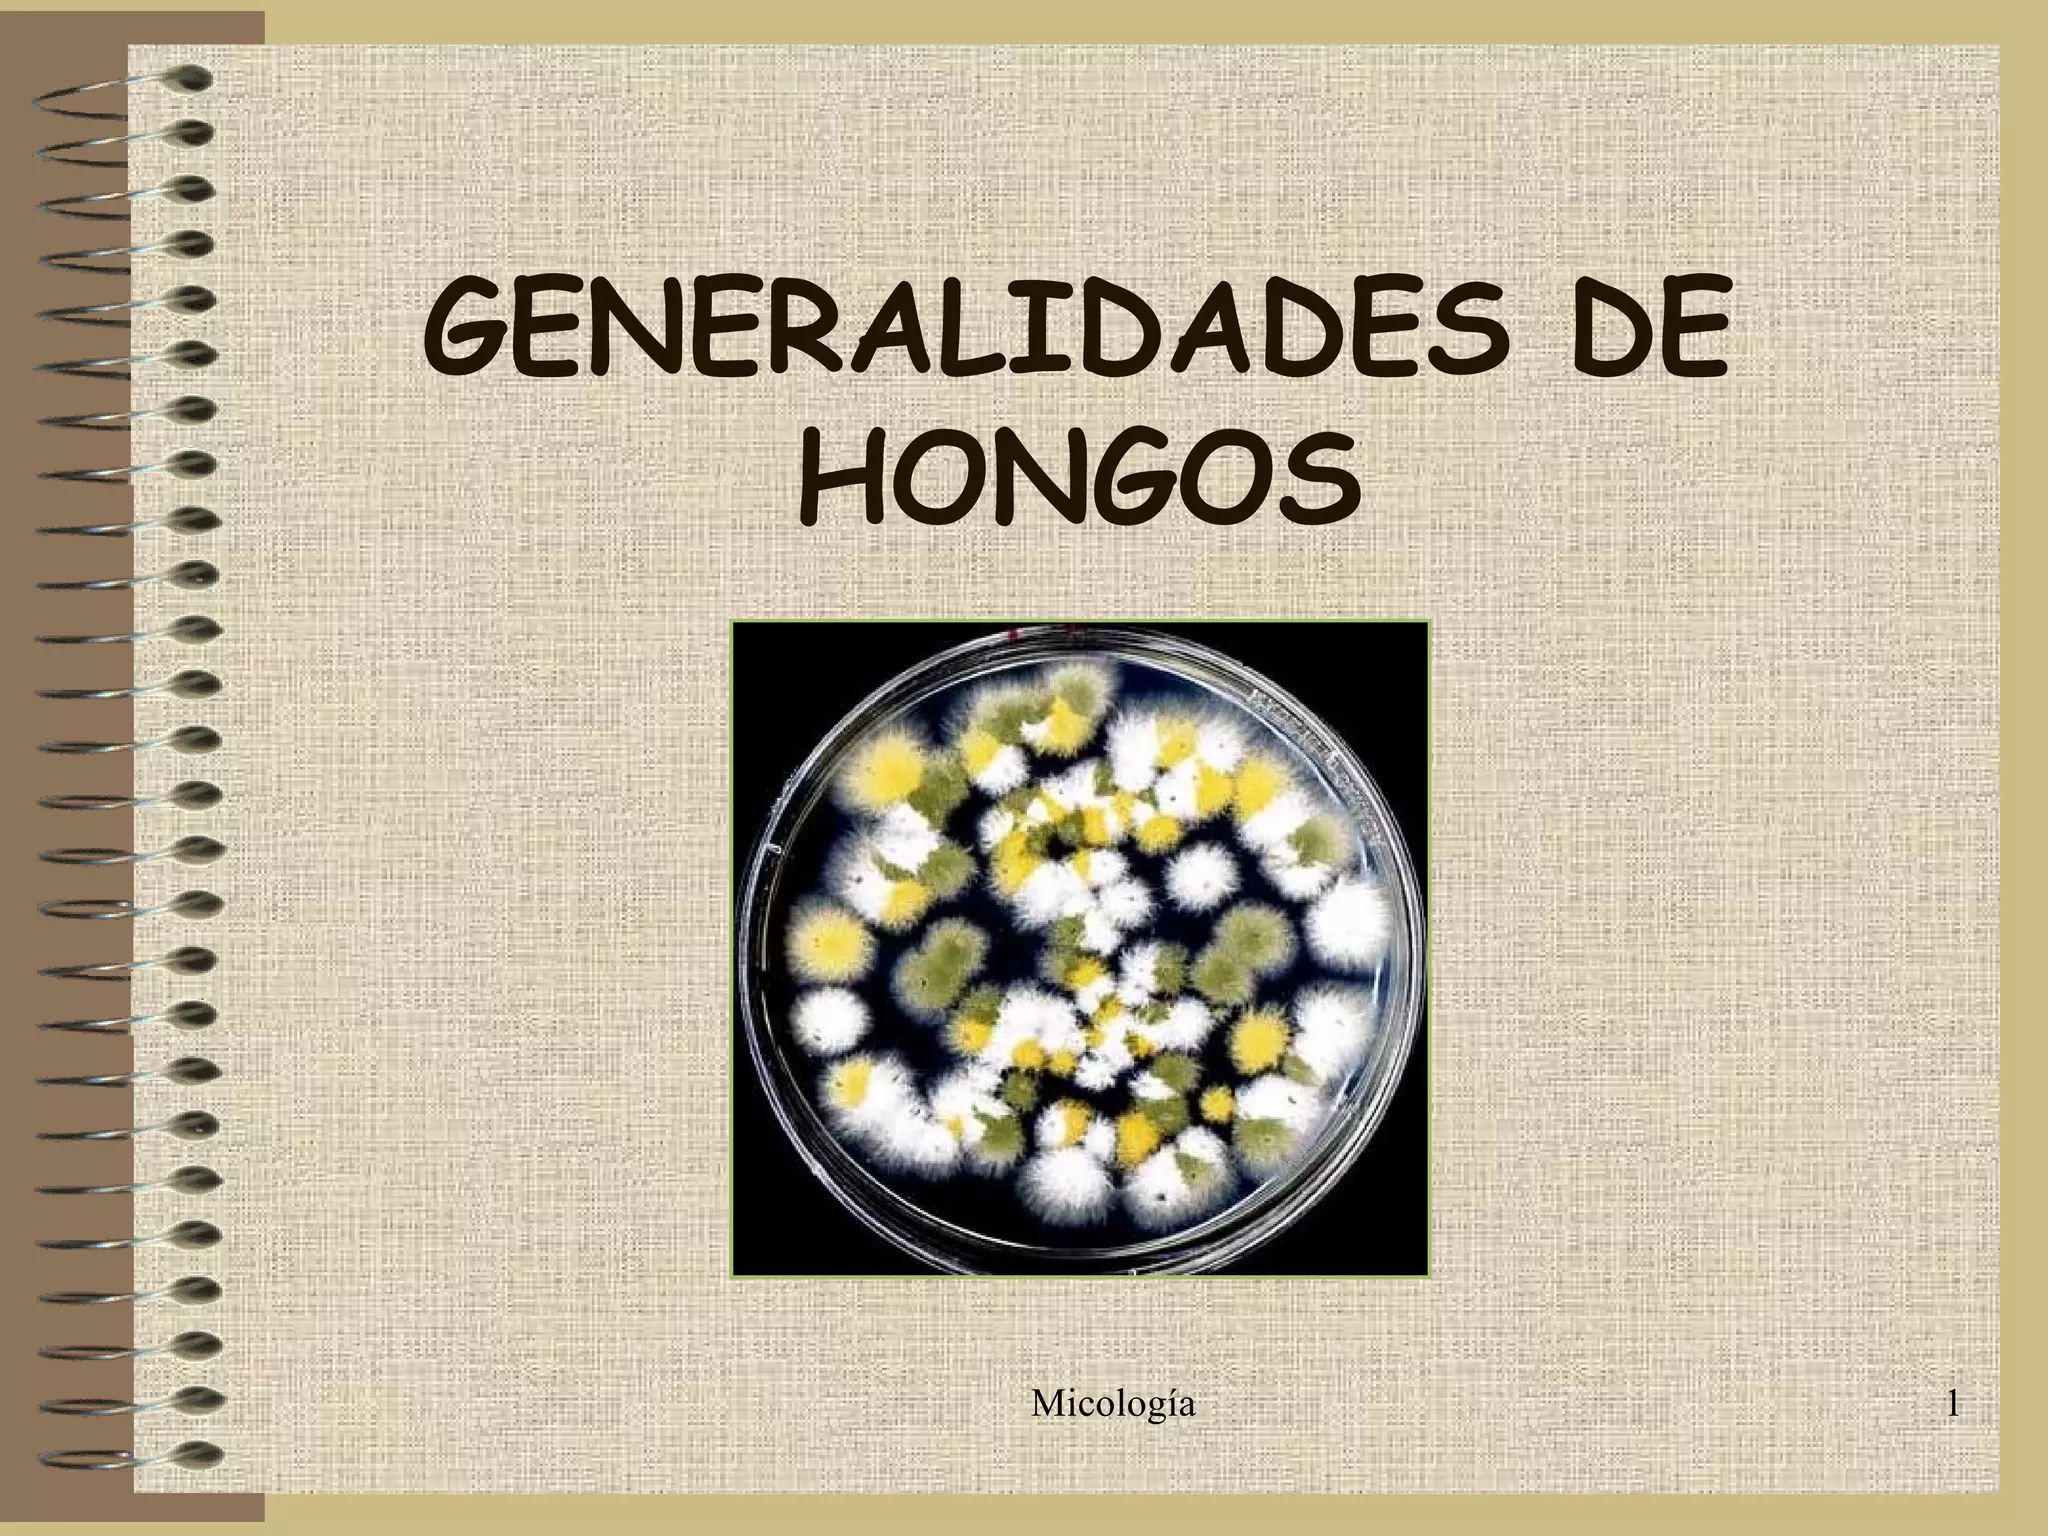

Este documento proporciona información sobre hongos y actinomicetales de importancia médica. Explica las características generales de los hongos, su clasificación, mecanismos de acción patógena, factores que posibilitan el desarrollo de micosis e información sobre actinomicetales.